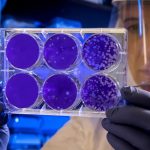

Canada Prime Minister’s Wife Infected with Coronavirus

 Hülya Karahan: Production Editor
Hülya Karahan: Production Editor
istanbulpostcomtr@gmail.com
“The Prime Minister is in good health and has no symptoms,” Sophie Gregoire Trudeau feels “good,” said his cabinet.
Canadian Prime Minister’s wife Sophie Gregoire Trudeau, was tested positive for the new coronavirus on Thursday and will be in quarantine “for an indefinite period”, while the head of government will remain in solitary confinement for two weeks.
Bu gönderiyi Instagram’da gör
“The Prime Minister is in good health and has no symptoms. However, as a precaution and according to the advice of doctors, he will be in solitary confinement for an expected period of 14 days, “announced the office of Justin Trudeau, adding that the Prime Minister’s wife felt” good “and that his symptoms remained “moderate”.
Justin Trudeau, 48, will not be tested “at this stage” and “will continue to perform his duties fully,” said his office, adding that the Prime Minister would speak to Canadians on Friday. His services had announced in the morning that the head of government had decided to work from home while his wife “gets tested for the Covid-19”. Sophie Gregoire Trudeau had had flu symptoms since returning from a trip to London.
Justin Trudeau called his Italian and British counterparts, Giuseppe Conte and Boris Johnson, as well as US President Donald Trump during the day, his cabinet said. On Friday, he will speak by telephone with the Premiers of the Canadian provinces to take stock of the fight against the epidemic, which has gained momentum in Canada in recent days. This meeting, initially scheduled in the presence of interested parties in Ottawa, was canceled in extremis due to coronavirus. In a personal message to Canadians, Justin Trudeau’s wife was reassuring about her own case.
“Although I have some unpleasant symptoms associated with the virus, I will get back on my feet soon,” she says. “I find myself in quarantine but nothing of my condition compares to the fate of other Canadian families whose health is more seriously affected. ” Canada reported Thursday more than 150 cases of coronavirus on its territory, most in Ontario (center) and British Columbia (west), with a single death to date. A child and baby became the first two miners to test positive in Canada on Thursday. A second retirement home is now affected in British Columbia.
With 13 cases, the Quebec government has announced a series of reinforced measures, calling in particular on travelers returning from abroad to place themselves in solitary confinement for two weeks. The provincial government, soon imitated by Alberta and then British Columbia (west), also banned indoor gatherings of more than 250 people. He called on Quebeckers to favor telework whenever possible.